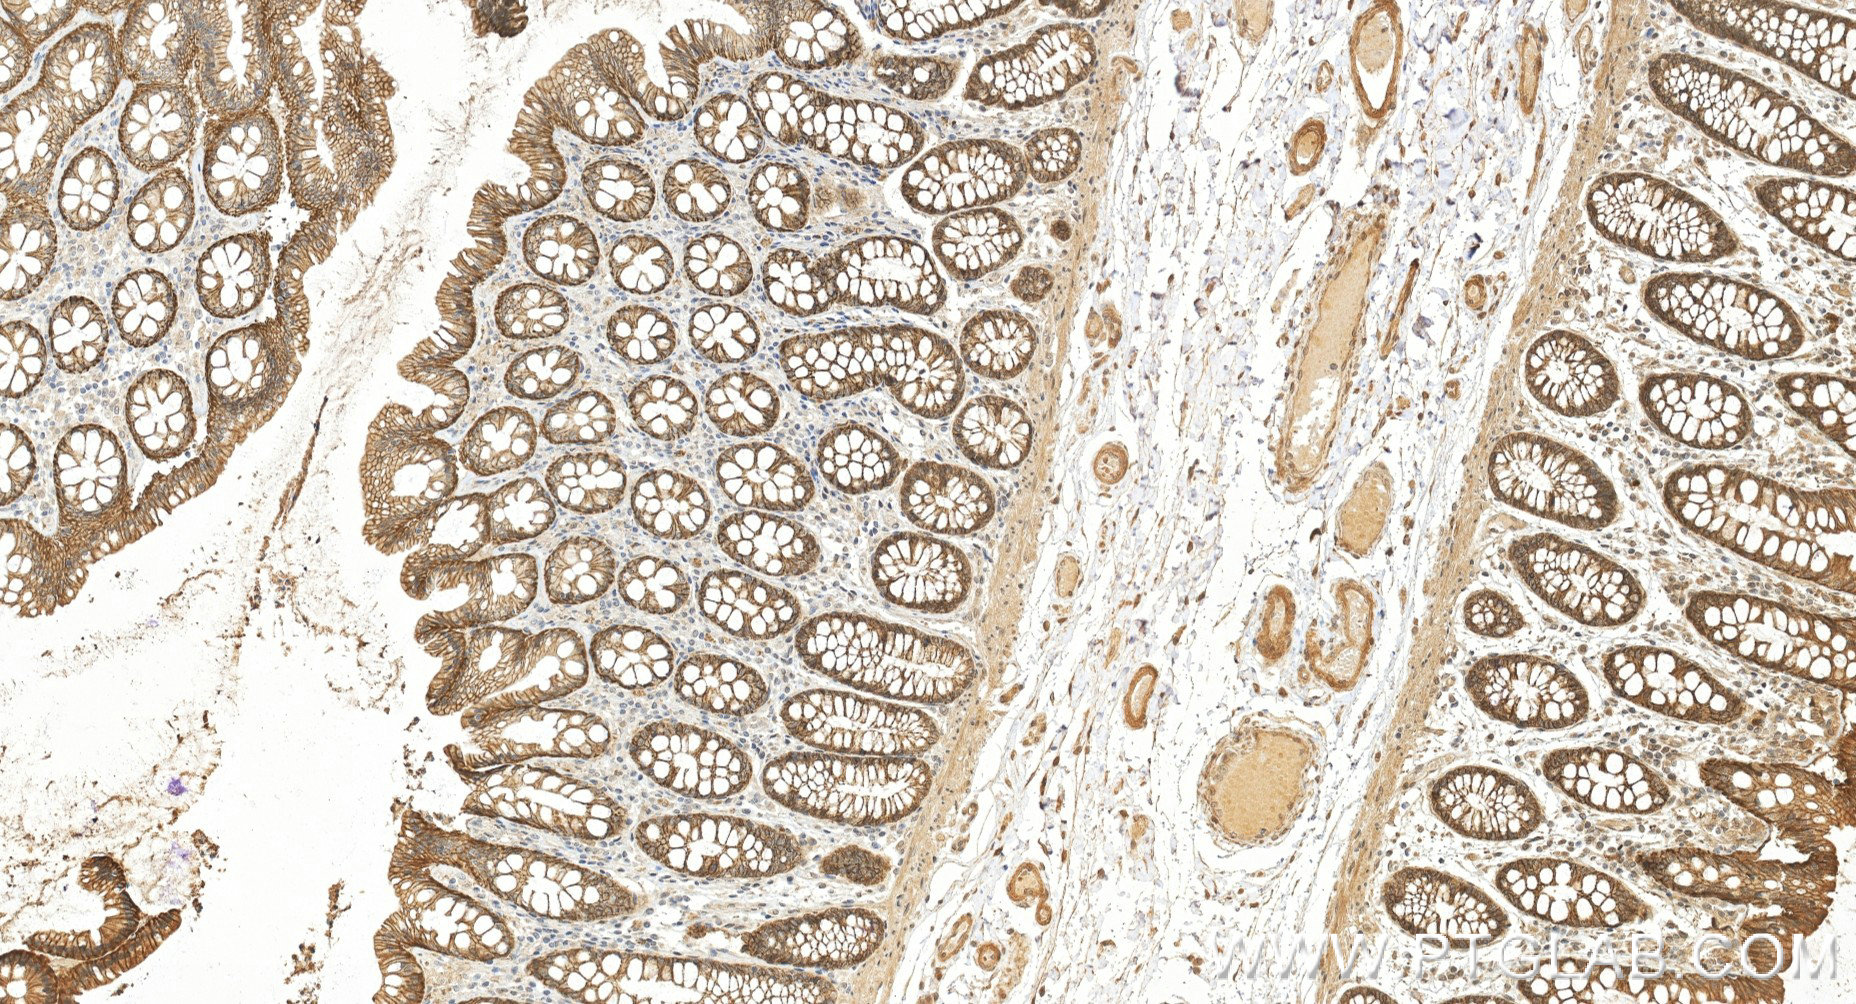

验证数据展示
产品信息
87085-1-PBS targets TRPM4 in WB, IHC, Indirect ELISA applications and shows reactivity with human samples.
| 经测试应用 | WB, IHC, Indirect ELISA Application Description |
| 经测试反应性 | human |
| 免疫原 |
Peptide 种属同源性预测 |
| 宿主/亚型 | Rabbit / IgG |
| 抗体类别 | Recombinant |
| 产品类型 | Antibody |
| 全称 | transient receptor potential cation channel, subfamily M, member 4 |
| 别名 | Calcium-activated non-selective cation channel 1, hTRPM4, Long transient receptor potential channel 4, LTrpC 4, LTrpC4 |
| 计算分子量 | 1214 aa, 134 kDa |
| 观测分子量 | 130~150 kDa |
| GenBank蛋白编号 | BC132727 |
| 基因名称 | TRPM4 |
| Gene ID (NCBI) | 54795 |
| 偶联类型 | Unconjugated |
| 形式 | Liquid |
| 纯化方式 | Protein A purification |
| UNIPROT ID | Q8TD43 |
| 储存缓冲液 | PBS only, pH 7.3. |
| 储存条件 | Store at -80°C. The product is shipped with ice packs. Upon receipt, store it immediately at -80°C |
背景介绍
TRPM4 is a Calcium-activated nonselective cation channel. It is activated by increase in intracellular Ca2+, mediates transport of monovalent cations (Na+ > K+ > Cs+ > Li+), leading to depolarize the membrane. It thereby plays a central role in cadiomyocytes, neurons from entorhinal cortex, dorsal root and vomeronasal neurons, endocrine pancreas cells, kidney epithelial cells, cochlea hair cells etc. TRPM4 participates in T-cell activation by modulating Ca2+ oscillations after T lymphocyte activation, which is required for NFAT-dependent IL2 production. It's also involved in myogenic constriction of cerebral arteries.